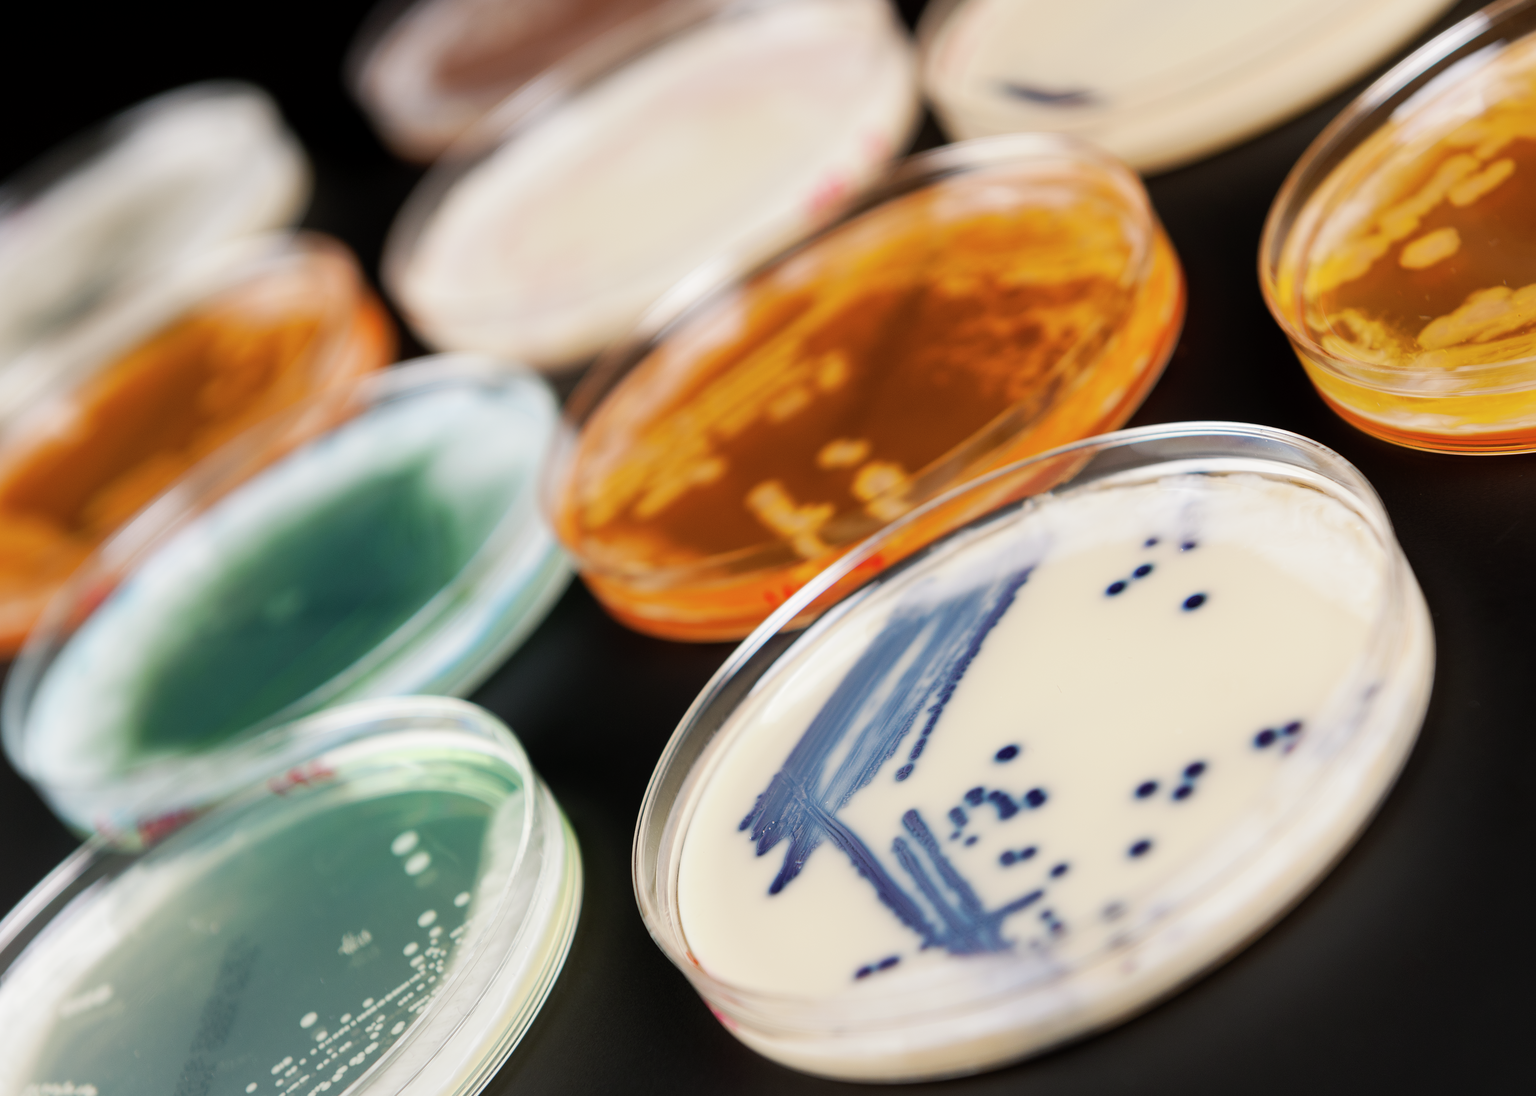
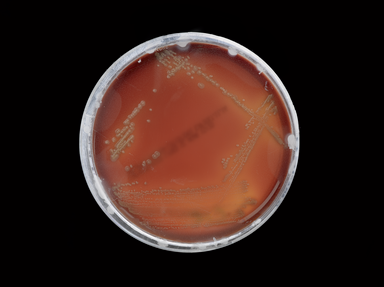
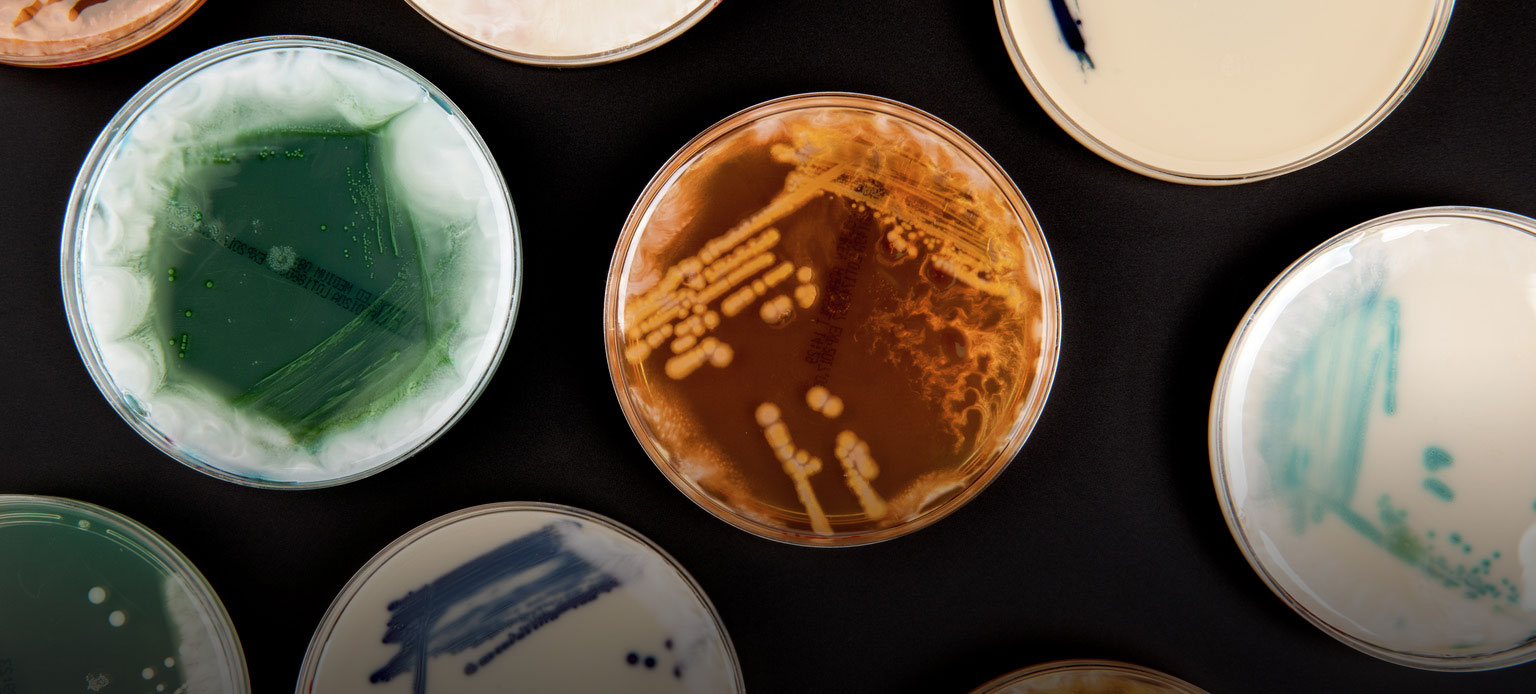

1. Their name reflects what they look like
 © Wellcome Images (CC)
© Wellcome Images (CC)
Bacteria are given two names—their genus and species—which are often descriptive of where the bacteria are found or what they look like.
So we end up with Staphylococcus aureus, which means “grape cluster berry” (Staphylococcus) and “golden” (aureus).
2. They can exist in extreme environments
Bacteria can be found living in the deepest oceans, the hottest deserts and have even survived a trip to outer space.
3. They have social awareness
Bacteria change their behaviour based on what other bacteria are around them. If a bacterium finds itself in a minority, it will lay low until it is surrounded by more of its own species.
Bacteria can also build themselves into huge communities called ‘biofilms’—colonies of millions of individuals that protect and cling to one another.
4. They have an impressive array of survival strategies
There’s all sorts going on in the tiny world of bacteria.
One species, Bdellovibrio bacteriovorus is a cannibal—it eats other bacteria. Bacteria also build bridges to share bits of DNA with each other, or they can hijack tiny viruses to do this instead.
5. They have superpowers
Bacteria with flagella, or spinning tails, can move up to a hundred times their body length in a second—a large fish can only move about ten times its body length in a second.
The strongest known organism ever is the sexually transmitted bacteria Neisseria gonorhoeae—it can pull 100,000 times its body weight. That’s the same as a human pulling 10,000 tonnes!
6. They are everywhere
Bacteria live all over our skin and can be spread easily by touch. This isn’t usually a problem, but in somewhere like a hospital where people are vulnerable to infections, this spread should be kept to a minimum.
One simple and effective way to stop bacteria spreading is a good handwashing. You don’t even need antibacterial soap, as the rubbing motion and water washes bacteria down the drain.
7. They thrive in space

Scientists found that bacteria that spent time on the International Space Station were much harder to kill with standard antibiotics than the stuff here on Earth (because of the effect of microgravity on the functioning of the bacteria).
Visit our free exhibition Superbugs: The Fight For Our Lives to see real bacteria and discover more about the global threat of antibiotic resistance. Open until Spring 2019.